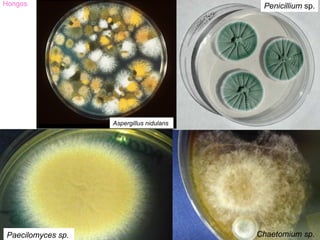
Hongos                                     Penicillium sp.




                   Aspergillus nidulans




Paecilomyces sp.                          Chaetomium sp.

El documento proporciona información sobre la diversidad del mundo microbiano. Brevemente describe los objetivos de conocer los microorganismos más importantes y sus características, así como las aplicaciones de la microbiología. También cubre la evolución microbiana, la clasificación de microorganismos, y la diversidad y cambiante clasificación de los microbios.






![Hongos
Levaduras
• hongos unicelulares
• reproducción asexual, frecuentemente por
gemación
• reproducción sexual por formación de
esporas
Mohos
• hongos filamentosos
– Hifa [hyphae (s., hypha)]
• filamento de un moho Hifa cenocítica
• puede ser cenocítico (sin Hifa septada
paredes transversales) o
septado (con paredes
transversales)
– mycelium (pl. mycelia)
• masa enredada o agregado
análogo a un tejido
Dimorfismo
algunos hongos cambian de la forma levadura (Y) a la de moho (M) (transformación YM)
en animales, Y en el huésped y M fuera del huésped
en plantas, M en el huésped e Y fuera del huésped](https://image.slidesharecdn.com/17-hongosalgasyprotozoos-090714072940-phpapp02/85/17-Hongos-Algas-Y-Protozoos-7-320.jpg)